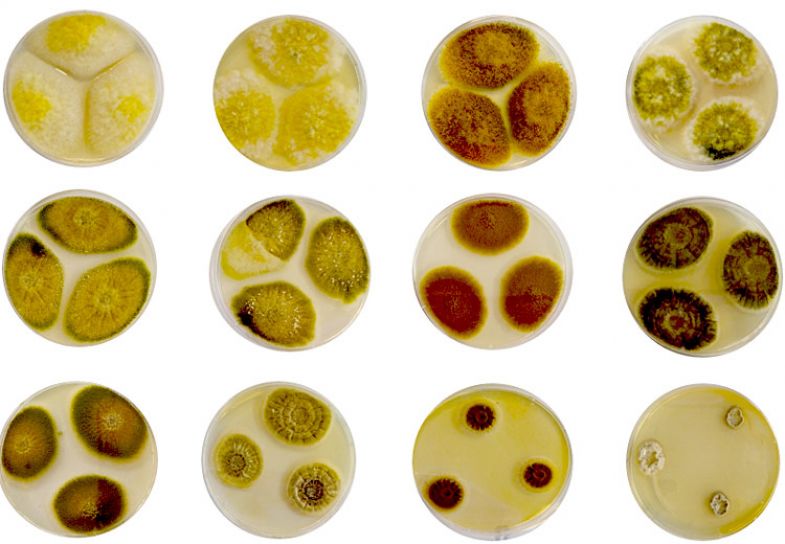

From left to right: Andrea Patriarca, lecturer in mycology, Angel Medina-Vaya, director of Environment and Agrifood, Carla Cervini, research fellow in applied food mycology and Carol Verheecke-Vaessen, lecturer in applied molecular mycology at Cranfield University
The Magan Centre for Applied Mycology at Cranfield University aims to explore the untapped world of fungi to find innovative solutions for the future
Scientists at Cranfield University are exploring new possibilities in the field of applied mycology by harnessing the tremendous potential of fungi to create sustainable solutions. The unexplored treasures of the world of fungi can bring promising solutions to tackle modern challenges and build a greener future, says Angel Medina-Vaya, professor of applied mycology and the director of Environment and Agrifood at Cranfield University.
“Fungi are very important,” says Medina-Vaya. “They are in all our lives already. However, these benefits come from a small proportion of known fungi.” Fungi can survive in harsh environments, making them beneficial in sustainability efforts, he adds. However, many types of fungi haven’t undergone comprehensive study, leaving their properties and benefits largely unexplored.
“This was an area that was completely underfunded. In the UK, there were pockets of people doing [research] in this area,” says Medina-Vaya. Supported by over £7 million in funding from Research England, Cranfield University is building a new research centre that will specialise in applied mycology. The new centre will explore potential uses of different types of fungi around the world and become a conduit for creating innovative products to tackle climate change.
“The centre is expanding the excellence at Cranfield University in different areas,” says Medina-Vaya. It will act as a hub for interdisciplinary collaboration to discover how fungi can be used to develop modern solutions and tackle global issues, such as building a greener economy and achieving net zero carbon emissions. Researchers at the centre will also explore how fungi can be used to propel growth in fields such as mycomaterials, sustainable manufacturing, mycoremediation, food security, bioenergy and recycling.
The Magan Centre for Applied Mycology at Cranfield University will explore potential applications of fungi
Championing equality, diversity and inclusion was an important consideration from the proposal stage of the centre, says Medina-Vaya. “We are trying to create an environment that everybody will be proud to work from,” he says.
Before embarking on the project, Medina-Vaya and his colleagues attended a training session on inclusivity and accessibility and discussed how the centre’s physical layout could be optimised to suit the needs and requirements of everyone involved. In pursuit of this objective, the facilities at the centre will include multiple lifts, wheelchair access, adaptable lighting in various shades, sensory rooms and lactation rooms.
Medina-Vaya adds that the team will review the facilities available at the centre every six months to keep up with advancements in technology. Additionally, they have allocated a specific budget for acquiring new technologies that will enhance accessibility.
Medina-Vaya and his colleagues are also taking an innovative approach to recruitment. His team has adopted recruitment strategies that encourage people from diverse backgrounds to apply. These include using more accessible language and visual elements in job advertisements and posting them on accessible platforms to enhance visibility and broaden their reach.
The recruitment team will measure the success of these strategies with each round of recruitment at the centre and modify their strategy based on the results. “We are doing things that are supported by publications and the research that we have done on equality, diversity and inclusion,” says Medina-Vaya.
Mentoring is an important part of achieving the goals of inclusivity and diversity, says Medina-Vaya. “At the moment, organisations aren’t making the right use of the mentorship approach,” he says. Medina-Vaya believes that considering principles of equality, diversity and inclusion when assigning mentors will be more effective in creating a supportive and empowering environment for everyone. “We need mentors to help people thrive.”
Find out more about the Magan Centre for Applied Mycology at Cranfield University.



